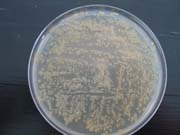
netted scab 180

About cookies
What is a "cookie"?
A "cookie" is a piece of information, usually small and identified by a name, which may be sent to your browser by a website you are visiting. Your web browser will store it for a period of time, and send it back to the web server each time you log on again.
Different types of cookies are placed on the sites:
- Cookies strictly necessary for the proper functioning of the site
- Cookies deposited by third party sites to improve the interactivity of the site, to collect statistics
Learn more about cookies and how they work
The different types of cookies used on this site
Cookies strictly necessary for the site to function
These cookies allow the main services of the site to function optimally. You can technically block them using your browser settings but your experience on the site may be degraded.
Furthermore, you have the possibility of opposing the use of audience measurement tracers strictly necessary for the functioning and current administration of the website in the cookie management window accessible via the link located in the footer of the site.
Technical cookies
Name of the cookie | Purpose | Shelf life |
|---|---|---|
CAS and PHP session cookies | Login credentials, session security | Session |
Tarteaucitron | Saving your cookie consent choices | 12 months |
Audience measurement cookies (AT Internet)
Name of the cookie | Purpose | Shelf life |
|---|---|---|
atid | Trace the visitor's route in order to establish visit statistics. | 13 months |
atuserid | Store the anonymous ID of the visitor who starts the first time he visits the site | 13 months |
atidvisitor | Identify the numbers (unique identifiers of a site) seen by the visitor and store the visitor's identifiers. | 13 months |
About the AT Internet audience measurement tool :
AT Internet's audience measurement tool Analytics is deployed on this site in order to obtain information on visitors' navigation and to improve its use.
The French data protection authority (CNIL) has granted an exemption to AT Internet's Web Analytics cookie. This tool is thus exempt from the collection of the Internet user's consent with regard to the deposit of analytics cookies. However, you can refuse the deposit of these cookies via the cookie management panel.
Good to know:
- The data collected are not cross-checked with other processing operations
- The deposited cookie is only used to produce anonymous statistics
- The cookie does not allow the user's navigation on other sites to be tracked.
Third party cookies to improve the interactivity of the site
This site relies on certain services provided by third parties which allow :
- to offer interactive content;
- improve usability and facilitate the sharing of content on social networks;
- view videos and animated presentations directly on our website;
- protect form entries from robots;
- monitor the performance of the site.
These third parties will collect and use your browsing data for their own purposes.
How to accept or reject cookies
When you start browsing an eZpublish site, the appearance of the "cookies" banner allows you to accept or refuse all the cookies we use. This banner will be displayed as long as you have not made a choice, even if you are browsing on another page of the site.
You can change your choices at any time by clicking on the "Cookie Management" link.
You can manage these cookies in your browser. Here are the procedures to follow: Firefox; Chrome; Explorer; Safari; Opera
For more information about the cookies we use, you can contact INRAE's Data Protection Officer by email at cil-dpo@inrae.fr or by post at :
INRAE
24, chemin de Borde Rouge -Auzeville - CS52627 31326 Castanet Tolosan cedex - France
Last update: May 2021